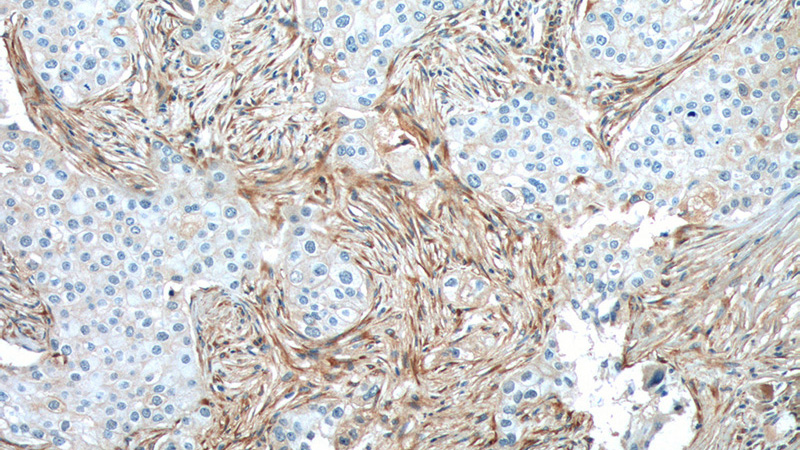
Immunohistochemistry of paraffin-embedded human breast cancer tissue slide using Catalog No:109375(COL1A2 Antibody) at dilution of 1:200 (under 10x lens). heat mediated antigen retrieved with Tris-EDTA buffer(pH9).

-
Product Name
Collagen Type I antibody
- Documents
-
Description
Collagen Type I Rabbit Polyclonal antibody. Positive WB detected in human kidney tissue, hVFFA8 cells. Positive IHC detected in human breast cancer tissue. Observed molecular weight by Western-blot: 160 kDa, 30 kDa, 129 kDa
-
Tested applications
ELISA, WB, IHC
-
Species reactivity
Human, Mouse; other species not tested.
-
Alternative names
Alpha 2 type I collagen antibody; COL1A2 antibody; Collagen alpha 2(I) chain antibody; Collagen Type I antibody; collagen antibody; type I antibody; alpha 2 antibody; OI4 antibody
- Immunogen
-
Isotype
Rabbit IgG
-
Preparation
This antibody was obtained by immunization of Collagen Type I recombinant protein (Accession Number: NM_000089). Purification method: Antigen affinity purified.
-
Clonality
Polyclonal
-
Formulation
PBS with 0.02% sodium azide and 50% glycerol pH 7.3.
-
Storage instructions
Store at -20℃. DO NOT ALIQUOT
-
Applications
Recommended Dilution:
WB: 1:200-1:2000
IHC: 1:50-1:500
-
Validations

human kidney tissue were subjected to SDS PAGE followed by western blot with Catalog No:109375(COL1A2 antibody) at dilution of 1:500

WB result of Collagen Type I antibody (Catalog No:109375, 1:2000) with hVFFA8 cells lysate.
Immunohistochemistry of paraffin-embedded human breast cancer tissue slide using Catalog No:109375(COL1A2 Antibody) at dilution of 1:200 (under 10x lens). heat mediated antigen retrieved with Tris-EDTA buffer(pH9).

Immunohistochemistry of paraffin-embedded human breast cancer tissue slide using Catalog No:109375(COL1A2 Antibody) at dilution of 1:200 (under 40x lens). heat mediated antigen retrieved with Tris-EDTA buffer(pH9).
-
Background
Type I collagen, the major structural component of connective tissues such as skin, tendon and bone, is the most abundant and widely expressed collagen in humans (PMID: 7620364; 8645190; 9016532). Type I collagen is a heterotrimer comprising one alpha 2(I) and two alpha 1(I) chains which are encoded by the unlinked loci COL1A2 and COL1A1 respectively. Mutations in COL1A2 gene are associated with osteogenesis imperfecta, Ehlers-Danlos syndrome, idiopathic osteoporosis, and atypical Marfan syndrome.
-
References
- Zhang Q, Xiao X, Li M. Attenuating effect of Fufang Xueshuantong Capsule on kidney function in diabetic nephropathy model. Journal of natural medicines. 67(1):86-97. 2013.
- Sataranatarajan K, Feliers D, Mariappan MM. Molecular events in matrix protein metabolism in the aging kidney. Aging cell. 11(6):1065-73. 2012.
- Yang J, Zhu HH, Chen GP. Inhibition of farnesyl pyrophosphate synthase attenuates angiotensin II-induced cardiac hypertrophy and fibrosis in vivo. The international journal of biochemistry & cell biology. 45(3):657-66. 2013.
- Liu T, Wang P, Cong M, Xu Y, Jia J, You H. The CYP2E1 inhibitor DDC up-regulates MMP-1 expression in hepatic stellate cells via an ERK1/2- and Akt-dependent mechanism. Bioscience reports. 33(3):. 2013.
- Xu D, Yang W, Hu Y. Surface functionalization of titanium substrates with cecropin B to improve their cytocompatibility and reduce inflammation responses. Colloids and surfaces. B, Biointerfaces. 110:225-35. 2013.
- Xing J, Li Y, Lin M. Surface chemistry modulates osteoblasts sensitivity to low fluid shear stress. Journal of biomedical materials research. Part A. 102(11):4151-60. 2014.
- Cui H, Yi Q, Feng J, Yang L, Tang L. Mechano growth factor E peptide regulates migration and differentiation of bone marrow mesenchymal stem cells. Journal of molecular endocrinology. 52(2):111-20. 2014.
- Ahram DF, Cook AC, Kecova H, Grozdanic SD, Kuehn MH. Identification of genetic loci associated with primary angle-closure glaucoma in the basset hound. Molecular vision. 20:497-510. 2014.
Related Products / Services
Please note: All products are "FOR RESEARCH USE ONLY AND ARE NOT INTENDED FOR DIAGNOSTIC OR THERAPEUTIC USE"
